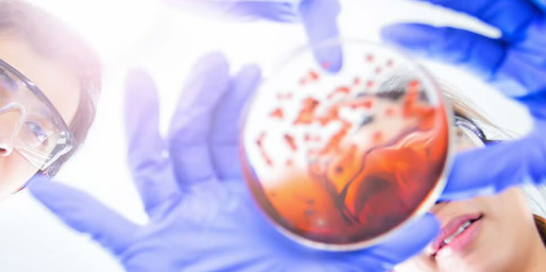

III CURSO DE ARTROSCOPIA DE MUÑECA
Los días 6 y 7 de Junio se celebró la 3ª Edición del Curso de Artroscopia de Muñeca, dirigido por los Dres Vicente Carratalá, Francisco Javier Lucas (ambos del Hospital Quirón Salud de Valencia) y Cristóbal Martínez, (Hospital Dos de Maig-Trauma Unit-Hospital Teknon-Quirón de Barcelona). El curso teórico-práctico en especimen, orientado a residentes de 5º año [...]